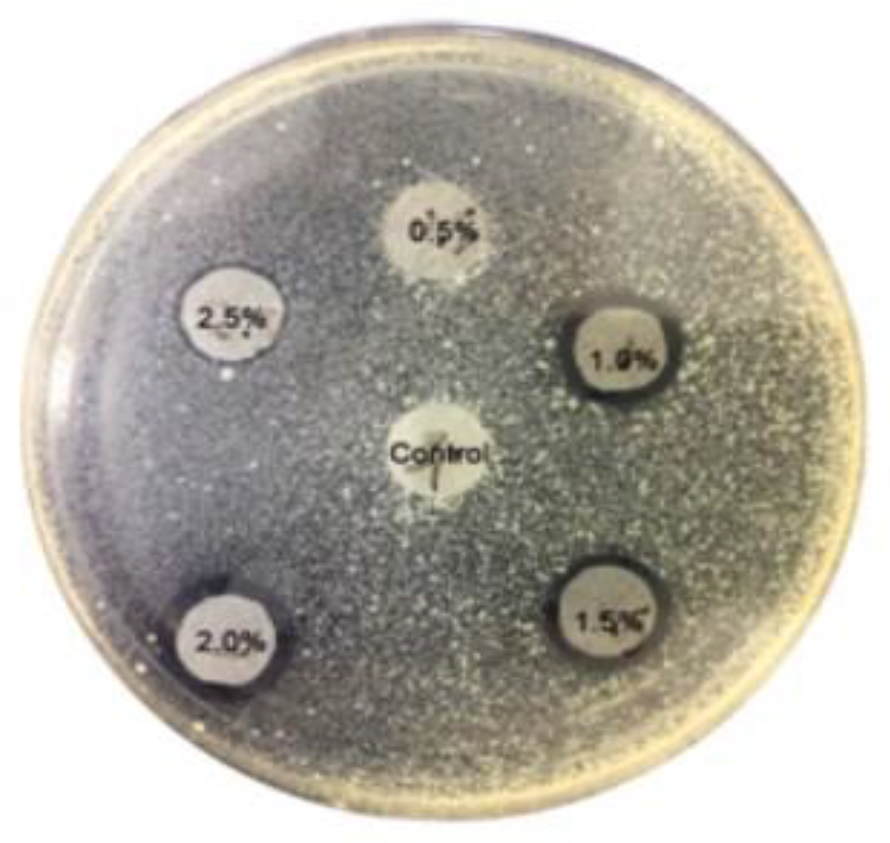
Applsci 14 07431 g007

Study of the Improvement of Disintegration Efficiency and Antibacterial Properties of Disposable Toilet Seat Cover Sheet Made of Cellulose Fibers
Abstract
1. Introduction
2. Materials and Methods
2.1. Raw Materials
2.2. Test for Antibacterial Test
2.3. Water Resistance Test
2.4. SEM Image
2.5. Testing Methods for Physical Properties
3. Results and Discussion
3.1. Disintegration Rate
3.2. Sizing Degree and Contact Angle
3.3. Physical Properties
3.4. Antibacterial Test
4. Conclusions
Author Contributions
Funding
Institutional Review Board Statement
Informed Consent Statement
Data Availability Statement
Conflicts of Interest
References
- Hadley, T.; Hickey, K.; Lix, K.; Sharma, S.; Berretta, T.; Navessin, T. Flushed but not forgotten: The rising costs and opportunities of disposable wet wipes. BioResources 2023, 18, 2271. [Google Scholar] [CrossRef]
- Rizan, C.; Reed, M.; Bhutta, M.F. Environmental impact of personal protective equipment distributed for use by health and social care services in England in the first six months of the COVID-19 pandemic. J. R. Soc. Med. 2021, 114, 250–263. [Google Scholar] [CrossRef] [PubMed]
- Roberts, K.P.; Phang, S.C.; Williams, J.B.; Hutchinson, D.J.; Kolstoe, S.E.; Bie, J.; Williams, I.D.; Stringfellow, A.M. Increased personal protective equipment litter as a result of COVID-19 measures. Nat. Sustain. 2022, 5, 272–279. [Google Scholar] [CrossRef]
- Imran, M.A.; Khan, M.Q.; Salam, A.; Ahmad, A. Cotton in Non-Woven Products. In Cotton Science and Processing Technology; Springer: Singapore, 2020; pp. 305–332. [Google Scholar]
- Allison, T.; Ward, B.D.; Harbottle, M.; Durance, I. Do flushed biodegradable wet wipes really degrade? Sci. Total Environ. 2023, 894, 164912. [Google Scholar] [CrossRef] [PubMed]
- Atasağun, H.G.; Bhat, G.S. Advancement in flushable wipes: Modern technologies and characterization. J. Ind. Text. 2020, 49, 722–747. [Google Scholar] [CrossRef]
- Joksimovic, D.; Khan, A.; Orr, B. Inappropriate disposal of ‘flushable’ consumer products—Reasons for concern. Water Sci. Technol. 2020, 81, 102–108. [Google Scholar] [CrossRef]
- Evey, G.A. Paper Toilet Seat Covers: Health Necessity or Environmental Detriment? California State Science Fair Project Summary. 2015. Available online: https://csef.usc.edu/History/2015/Projects/S1108.pdf (accessed on 19 August 2024).
- Research Reports. Disposable Toilet Potty Seat Covers Market Size: Analyzing Trends and Projected Outlook for 2023–2030. 2023. Available online: https://www.linkedin.com/pulse/disposable-toilet-potty-seat-covers-market-size-analyzing (accessed on 19 August 2024).
- Sun, K.S.; Lam, T.P.; Tang, W.S.; Chan, H.Y.; Lam, K.F.; Chow, E.C.Y.; Ho, P.L. Improving public toilet environment and hygiene practices in an Asian city: Voices from Hong Kong residents. Asia Pac. J. Public Health 2021, 33, 378–387. [Google Scholar] [CrossRef]
- Giannini, M.A.; Nance, D.; McCullers, J.A. Are toilet seats a vector for transmission of methicillin-resistant Staphylococcus aureus? Am. J. Infect. Control 2009, 37, 505–506. [Google Scholar] [CrossRef][Green Version]
- Sharma, D.; Chanchal, M.W. Anti-Odour Finished Disposable Toilet Seat Cover: An Innovative Approach. Int. J. Innov. Res. Sci. Eng. Technol. 2016, 5, 18961–18966. [Google Scholar]
- Raipale, N.; Heikkilä, P. SUSTAFIT–Sustainability Strategies for Non-Wovens; VTT Technical Research Centre of Finland: Espoo, Finland, 2024. [Google Scholar]
- Abel, O.T.; Ogundana, A.K. Preliminary Quality and Potential Assessment of Groundwater in the Basement Complex Terrain of Ijero-Ekiti, Southwestern Nigeria. Int. J. Innov. Res. Sci. Eng. Technol. 2014, 3, 8. [Google Scholar]
- Zhang, C.H.; Yang, F.L.; Wang, W.J.; Chen, B. Preparation and characterization of hydrophilic modification of polypropylene non-woven fabric by dip-coating PVA (polyvinyl alcohol). Sep. Purif. Technol. 2008, 61, 276–286. [Google Scholar] [CrossRef]
- Pantoja Munoz, L.; Gonzalez Baez, A.; McKinney, D.; Garelick, H. Characterisation of “flushable” and “non-flushable” commercial wet wipes using microRaman, FTIR spectroscopy and fluorescence microscopy: To flush or not to flush. Environ. Sci. Pollut. Res. 2018, 25, 20268–20279. [Google Scholar] [CrossRef] [PubMed]
- ISO 12625-17; Tissue Paper and Tissue Products—Part 17: Determination of Disintegration in Water. International Standard: Geneva, Switzerland, 2021.
- Park, N.; Lee, J.; Yoo, S.; Woo, K.; Kim, H. Evaluation of water release characteristics of domestically distributed tissue products. Pulp Pap. Technol. 2021, 53, 53–63. [Google Scholar]
- Penn, R.; Schuetze, M.; Jens, A.; Friedler, E. Tracking and simulation of gross solids transport in sewers. Urban Water J. 2018, 15, 584–591. [Google Scholar] [CrossRef]
- CLSI M02. Chapter 3. In Performance Standards for Antimicrobial Disk Susceptibility Tests, 14th ed.; Clinical and Laboratory Standards Institute: Wayne, PA, USA, 2024; Volume 21. [Google Scholar]
- Lee, J.-Y.; Kim, G.-C.; Kim, V.; Sheikh, M.I.; Park, H.-J.; Kim, S.-H.; Sim, S.-W.; Cho, H.-S. Automated test method of sizing degree by analysis of liquid penetration and its surface behavior. J. Korea TAPPI 2012, 44, 18–28. [Google Scholar]
- Lee, J.-Y.; Kim, C.-H.; Lee, J.; Nam, H.-G.; Lee, G.-S.; Jo, H.-S.; Park, H.-H. Evaluation of reliability of the automatic system for measuring sizing degree by basis weight variation of paper. J. Korea TAPPI 2014, 46, 11–19. [Google Scholar] [CrossRef][Green Version]
- Song, D.; Kim, C.-H.; Moon, S.-O. Automatic Stöckigt sizing test using an automatic recognition principle of color expression. Appita J. 2006, 59, 396–400. [Google Scholar]
- De Assis, T.; Reisinger, L.W.; Pal, L.; Pawlak, J.; Jameel, H.; Gonzalez, R.W. Understanding the effect of machine technology and cellulosic fibers on tissue properties—A review. BioResources 2018, 13, 4593–4629. [Google Scholar] [CrossRef]
- Korpela, A.; Jaiswal, A.K.; Asikainen, J. Effects of hydrophobic sizing on paper dry and wet-strength properties: A comparative study between AKD sizing of NBSK handsheets and rosin sizing of CTMP handsheets. BioResources 2021, 16, 5350. [Google Scholar] [CrossRef]
- Jin, H.; Okayama, T.; Arai, R.; Ohtani, H. Relationship between wettability and sizing degree of paper containing bulking agent. J. Wood Sci. 2011, 57, 34–39. [Google Scholar] [CrossRef]
- Taniguchi, R.; Isogai, A.; Onabe, F.; Usuda, M. Sizing mechanism of alkylketene dimers: Part 3. Appearance of sizing features of AKD-sized sheets. Nord. Pulp Pap. Res. J. 1993, 8, 352–357a. [Google Scholar] [CrossRef]
- Guo, X.; Dong, J.; Liu, H.; Duan, C.; Yang, R.; Qi, K.; Kong, L. Refining mechanism of combined refining plates with different bar angles. Pulp Pap. Technol. 2020, 52, 32–42. [Google Scholar] [CrossRef]
- Gharehkhani, S.; Sadeghinezhad, E.; Kazi, S.N.; Yarmand, H.; Badarudin, A.; Safaei, M.R.; Zubir, M.N.M. Basic effects of pulp refining on fiber properties—A review. Carbohydr. Polym. 2015, 115, 785–803. [Google Scholar] [CrossRef]
- Rochaeni, H.; Irawan, C.; Nurfitri, M.; Lestari, P.S.; Rosdianan, U. The Influence and the Analysis of Alkyl Ketene Dimers (AKD) to Paper Resistance in Water Absorption and Chemical Solution Penetration. In Proceedings of the International Conference on Science and Technology (ICST 2018), Yogyakarta, Indonesia, 18–19 October 2018; Atlantis Press: Amsterdam, The Netherlands, 2018; pp. 298–300. [Google Scholar]
- Kumar, Y.S.; Mahavir, S.; Santosh, G.; Rami Reddy, S.; Sarvjeet, S.; Reddy, K.P.; Rajinder, S. An Experience of Alkaline Sizing with AKD. IPPTA 2007, 19, 85. [Google Scholar]
- Lindström, T.; Larsson, P.T. Alkyl Ketene Dimer (AKD) sizing—A review. Nord. Pulp Pap. Res. J. 2008, 23, 202–209. [Google Scholar] [CrossRef]
- Isogai, A. Factors influencing on retention of Alkyl ketene dimer. Fundam. Papermak. Mater. 1997, 2, 1047–1071. [Google Scholar]
- Marton, M. Practical aspects of alkaline sizing—On kinetics of alkyl ketene dimer reactions: Hydrolysis of alkyl ketene dimer. Tappi J. 1990, 73, 139–143. [Google Scholar]
- Lindströmand, T.; Glad-Nordmark, G. A study of AKD-size retention, reaction and sizing efficiency. Part 4: The effects of pH, bicarbonate and metal ions on AKD-hydrolysis. Nord. Pulp Pap. Res. J. 2007, 22, 167–171. [Google Scholar] [CrossRef]
- Atasağun, H.G.; Bhat, G.S. Assessing the structural, mechanical and dispersible characteristics of flushable nonwovens. Text. Res. J. 2020, 90, 581–592. [Google Scholar] [CrossRef]
- Zhang, Y.; Xu, Y.; Zhao, Y.; Huang, C.; Jin, X. Effects of short-cut fiber type and water-jet pressure sum on wet strength and dispersibility of wood pulp-based wetlaid/spunlace wipes. Eur. J. Wood Wood Prod. 2019, 77, 33–43. [Google Scholar] [CrossRef]
- Seppänen, R.; Tiberg, F.; Valignat, M.P. Mechanism of internal sizing by alkyl ketene dimers (AKD): The role of the spreading monolayer precursor and autophobicity. Nord. Pulp Pap. Res. J. 2020, 15, 452–458. [Google Scholar] [CrossRef]
- Mu, M.; McFerrin, A. Influence of Surface Roughness, Nanostructure, and Wetting on Bacterial Adhesion. Langmuir 2023, 39, 5426–5439. [Google Scholar] [CrossRef] [PubMed]
- Joutsimo, O.; Wathén, R.; Tamminen, T. Effects of fiber deformations on pulp sheet properties and fiber strength. Pap. Ja Puu 2005, 87, 392. [Google Scholar]
- Wathén, R. Studies on Fiber Strength and Its Effect on Paper Properties. Ph.D. Thesis, Helsinki University, Helsinki, Finland, 2006. [Google Scholar]
- Borodulina, S.; Motamedian, H.R.; Kulachenko, A. Effect of fiber and bond strength variations on the tensile stiffness and strength of fiber networks. Int. J. Solids Struct. 2018, 154, 19–32. [Google Scholar] [CrossRef]
- Liu, H.; Dong, J.; Jing, H.; Guo, X.; Duan, C.; Qi, K.; Yang, R.; Guo, H.; Wang, B.; Qiao, L. Refining Characteristics of Isometric Straight Bar Plates with Different Bar Angles. BioResources 2020, 15, 7844. [Google Scholar] [CrossRef]
- Ryu, J.H.; Kim, C.H.; Lee, J.Y.; Lee, J.S.; Lee, C.H.; Park, J.H. Study of refining effect of mixed pulps using refiner plates with different bar patterns. Appl. Sci. 2022, 12, 11445. [Google Scholar] [CrossRef]
- Koskenhely, K. Effect of Selected Filling and Pulp Suspension Variables in Improving the Performance of Low-Consistency Refining. Ph.D. Thesis, Helsinki University of Technology, Helsinki, Finland, 2007; p. 49. [Google Scholar]
- Gu, H.G.; Min, B.G.; Lee, J.Y.; Park, S.H.; Lee, M.S.; Lee, C.Y.; Kim, C.H. Mechanical modification of softwood pulp fibers using a novel lightweight vertical bar plate. TAPPI J. 2021, 20, 241–451. [Google Scholar] [CrossRef]
- Pasquale, T.R.; Tan, J.S. Nonantimicrobial effects of antibacterial agents. Clin. Infect. Dis. 2005, 40, 127–135. [Google Scholar] [CrossRef] [PubMed]
- Ahmad, H. Celluloses as support materials for antibacterial agents: A review. Cellulose 2021, 28, 2715–2761. [Google Scholar] [CrossRef]
- Bojarski, B.; Kot, B.; Witeska, M. Antibacterials in Aquatic Environment and Their Toxicity to Fish. Pharmaceuticals 2020, 13, 189. [Google Scholar] [CrossRef]
- Löffler, P.; Escher, B.I.; Baduel, C.; Virta, M.P.; Lai, F.Y. Antimicrobial transformation products in the aquatic environment: Global occurrence, ecotoxicological risks, and potential of antibiotic resistance. Environ. Sci. Technol. 2023, 57, 9474–9494. [Google Scholar] [CrossRef] [PubMed]

| Chemical Types | Brand Name | Addition Level (%) 1 | Company |
|---|---|---|---|
| Alkyl ketene dimer | Hercon WI | 0, 0.2, 0.4, 0.6, 0.8., 1.0 | Solenis Korea, Gimcheon, Republic of Korea |
| Retention aid | SR-1700 | 0.2 | Dongjin Industry Co., Ltd., Daegu, Republic of Korea |
| Organic antibacterial agent | Zinc Omadine™ | 0, 0.5, 1, 1.5, 1.5, 2, 2.5 | Ahsung Fine Chemical Co., Ltd., Pyeongtaek, Republic of Korea |
Disclaimer/Publisher’s Note: The statements, opinions and data contained in all publications are solely those of the individual author(s) and contributor(s) and not of MDPI and/or the editor(s). MDPI and/or the editor(s) disclaim responsibility for any injury to people or property resulting from any ideas, methods, instructions or products referred to in the content. |
© 2024 by the authors. Licensee MDPI, Basel, Switzerland. This article is an open access article distributed under the terms and conditions of the Creative Commons Attribution (CC BY) license (https://creativecommons.org/licenses/by/4.0/).
Share and Cite
Park, J.-H.; Kim, C.-H.; Park, H.-H.; Lee, T.-G.; Park, M.-S.; Lee, J.-S. Study of the Improvement of Disintegration Efficiency and Antibacterial Properties of Disposable Toilet Seat Cover Sheet Made of Cellulose Fibers. Appl. Sci. 2024, 14, 7431. https://doi.org/10.3390/app14167431
Park J-H, Kim C-H, Park H-H, Lee T-G, Park M-S, Lee J-S. Study of the Improvement of Disintegration Efficiency and Antibacterial Properties of Disposable Toilet Seat Cover Sheet Made of Cellulose Fibers. Applied Sciences. 2024; 14(16):7431. https://doi.org/10.3390/app14167431
Chicago/Turabian StylePark, Ju-Hyun, Chul-Hwan Kim, Hyeong-Hun Park, Tae-Gyeong Lee, Min-Sik Park, and Jae-Sang Lee. 2024. "Study of the Improvement of Disintegration Efficiency and Antibacterial Properties of Disposable Toilet Seat Cover Sheet Made of Cellulose Fibers" Applied Sciences 14, no. 16: 7431. https://doi.org/10.3390/app14167431
APA StylePark, J.-H., Kim, C.-H., Park, H.-H., Lee, T.-G., Park, M.-S., & Lee, J.-S. (2024). Study of the Improvement of Disintegration Efficiency and Antibacterial Properties of Disposable Toilet Seat Cover Sheet Made of Cellulose Fibers. Applied Sciences, 14(16), 7431. https://doi.org/10.3390/app14167431

